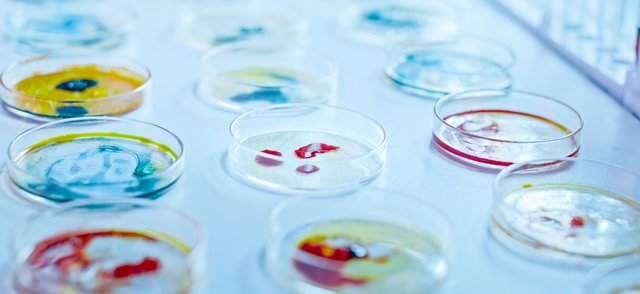
Microbiology.png

The University of Liverpool’s Nanotherapeutics Hub has joined the Infection Innovation Consortium (iiCON) to help support the discovery and development of new products and treatments for infectious diseases.
The Nanotherapeutics Hub will work with iiCON to support companies looking to develop nanotherapetuics to combat infectious diseases and access the nanomedicne market, which is expected to be worth $169 billion USD by 2026.
The Nanotherapeutics Hub will support companies by providing advanced analytical capabilities and expertise on biocompatibility, biodistribution and pharmacokinetics, physical and chemical characterisation, and the development of better models to improve therapeutic delivery to the biological target site whilst ensuring patient safety.
Led by the Liverpool School of Tropical Medicine (LSTM) and backed by UKRI’s Strength in Places Fund (SIPF), iiCON is aiming to strengthen the UK’s infectious diseases product pipeline. The consortium supports industry in bringing new game-changing therapeutics and products to market in response to the growing global threat of infectious diseases and antimicrobial resistance (AMR).
Professor Janet Hemingway, who leads the Infection Innovation Consortium (iiCON), said: “We’re delighted to welcome The Nanotherapeutics Hub as an iiCON platform. It is a centre of excellence for nanotherapeutics in the UK and is doing important work to support the development of nanomedicine by driving forward innovation and R&D and connecting global expertise and capability.
“Nanomedicine is an extremely exciting field that is improving the performance and efficacy of existing drugs and treatments. It is also enabling the development of innovative therapeutic pathways and is a key weapon in our battle to tackle infectious diseases and combat antibiotic resistance.
“As a member of iiCON, The Nanotherapeutics Hub will play a valued role in supporting companies working at the cutting-edge of drug discovery; providing them with world-class expertise and analytical capability that will expedite their product development pathways and help to bring new, impactful treatments to market that will reduce the global burden of infectious disease.”
Dr Neill Liptrott, coordinator of the Nanotherapeutics Hub, said: “We are very pleased to join iiCON and bring with us our expertise in the field of nanotherapeutics which, to date, encompasses applications in infectious disease, cancer, immune modulation and regenerative medicine. The benefits, and promise, of nanotechnology are clear however, robust characterisation of their interactions with biological systems is vital to their translation to clinical use.
“Using our expertise, we are determining critical quality attributes for nanotherapeutics to assist in future rational design of advanced materials. This is supported by our partnership with the National Measurement Laboratory and our links into national, and international, activities. We look forward to being part of iiCON and supporting the partners in their efforts to combat existing, and emerging, infectious diseases.”

